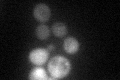
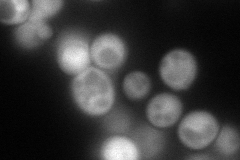
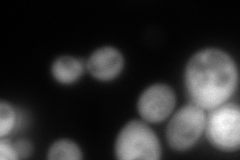
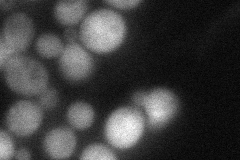

View description
6-phosphogluconolactonase with similarity to Sol3p
Localization:
Intensity:
Fold change:
Significance:
-
C’ GFP library in SD
cytosol61.85 -
N' NOP1pr-GFP in SD
cytosol152.296 -
N' TEF2pr-mCherry in SD
cytosol288.011 -
N' NATIVEpr-GFP in SD
cytosol38.8232 -
N' TEF2pr-VC and Cyto-VN in SD

cytosol67.6089 -
C’ GFP library in SD+DTT

cytosol95.21.53Yes -
C’ GFP library in SD+H2O2

cytosol81.321.31No -
C’ GFP library in Starvation Media

nucleusN/AN/AYes -
C’ GFP library on the background of Pup2-DaMP

cytosol -
C’ GFP library on the background of CCT mutant

cytosol74.88461.21059No
